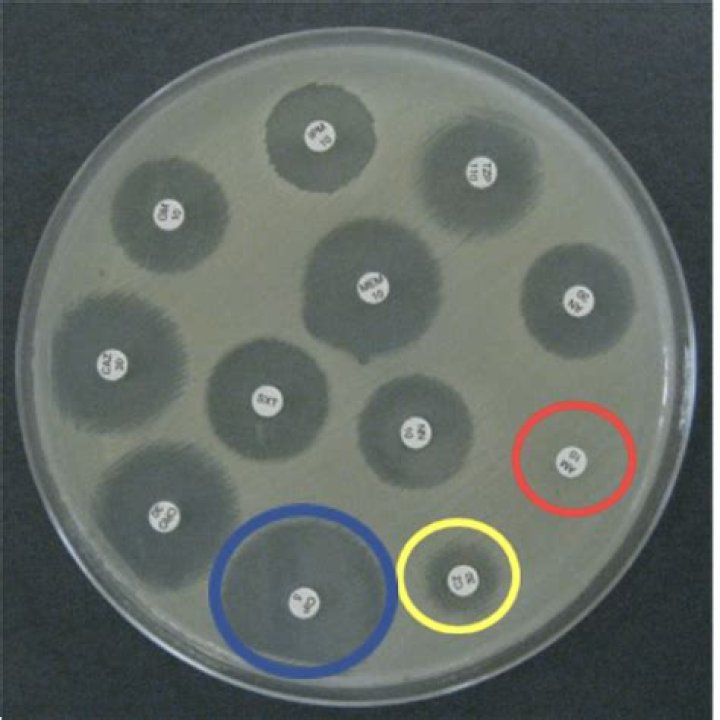

How long can olives stay out of the fridge

Olives Don’t Usually Require Refrigeration (Unless They Are Served Dry) Olives left in their brine or liquid can stay out overnight without any problem. In fact, olives kept in their liquid can stay out of the refrigerator for up to six months, provided they don’t get exposed to extreme heat.
Can olives go bad if not refrigerated?
Olives can be safely left out on the counter for a few hours, but they should then be returned to the refrigerator. If too much time has passed and the olives appear to have spoiled, they should be thrown away. Spoiled olives will have a different color, odor, or texture.
Can olives go bad and make you sick?
The symptoms of eating food past its expiration date can vary. With olives, you may just have a stomachache for a few hours. This may be accompanied by diarrhea and vomiting. Do keep in mind that it’s possible to get food poisoning from olives if they’ve grown mold.
How long do olives last out of the fridge?
Do jars and tubs of olives need to be refrigerated after the container is opened? The company said no, if they are handled correctly. That means if the olives are kept submerged in their brine and kept out of heat and direct sunlight, they will last up to six months at room temperature.How long does an open jar of green olives last in the fridge?
Opened liquid-free olives usually last up to 3 days. Liquid packed ones typically keep for at least a week or two, but often much longer if you take good care of them. Refrigerate the olives after opening. Make sure they are submerged in brine or any other liquid they come in.
How long does it take for olives to go bad?
PantryFridgeOlives in brine (unopened)Best-by + 3 – 6 monthsOlives in brine (opened)3 weeksOlives in oil (unopened or opened)Date on the label + 2 – 4 weeks
How can you tell if olives are bad?
How can you tell if opened olives are bad or spoiled? The best way is to smell and look at the olives: if the olives develop an off odor, flavor or appearance, or if mold appears, they should be discarded. Discard all olives from cans or bottles that are leaking, rusting, bulging or severely dented.
Do black olives have to be refrigerated after opening?
Once you have opened a can, store the olives completely submerged in their own liquid in a covered container in the refrigerator for one to two weeks. Olives bought in bulk and stored steeped in oil keep several months in the refrigerator. Discard olives that have turned soft.Can olives go off?
The short answer is yes, olives do go bad. That said, it usually takes a pretty long time for that to happen if they were in good condition when you bought ’em and they’ve been properly stored since.
How do you store olives at home?Store in a cool, dark place for six weeks before eating. The olives will keep for up to two years unopened. Once opened, store in the fridge, where they will keep for up to six months.
Article first time published onCan olives have botulism?
Organic Isn’t Always Safer When It Comes To Botulism : The Salt An outbreak of botulism linked to organic Italian olives makes it clear that even food that sounds pristine can harbor deadly pathogens.
What is the white stuff in olive jars?
Speaking of olives, when the jar of green olives gets a little white film on top, don’t toss them. This is known as “mother” and is not harmful. You can scoop it off with a spoon, and then add a teaspoon of vinegar to the jar to help prevent it from forming again.
Can you get botulism from green olives?
After multivariate analysis, only the risk associated with eating green olives remained significant (RR 5.2, 95% CI 1.4–19.8). None of the food items served on February 22 or 24 was available for sampling, and none of the other 13 food samples obtained from the restaurant was positive for C. botulinum.
Can green olives get moldy?
Olive manufacturers say olives last for up to 12 months in the jar in the refrigerator. … If white film or mold develops, simply remove it by tipping over the jar and pouring out the film. You can add a teaspoon or so of vinegar to the jar to keep this film from forming. The olives still should be safe to eat.
What olives are used in pizza?
Sliced black olives are used mainly as toppings on sandwiches and pizzas or used to flavour pastas etc. Black olives are usually stuffed with pimentos, peppers, garlic, dry fruits like almonds etc. One can also stuff black olives with cheese, meat etc and then use in recipes.
Do oil cured olives need refrigeration?
Keep olive-cured olives moist (drizzle olive oil over them if they look dry) and store them in the refrigerator.
Why do my green olives have black spots?
These spots are natural bruising and freckling that occur in picking/harvesting. The olives are still delicious and safe to eat. Black olives also have these bruises but this bruising is not visible because of the olive’s dark color.
Can of olives have white stuff in it?
The white stuff is most common called Mother or Mother of Vinegar. It is a harmless residue (oxidation) that forms on the olives when the vinegar in the brine mixes with oxygen. It is a naturally occurring by-product of the vinegar bacteria itself.
What happens if you eat a lot of olives?
Moderation is key Though olives may aid weight loss, they’re high in salt and fat — and eating too many of them may offset your weight loss success. As such, you should moderate your intake, limiting yourself to a few ounces at most per day.
Why do olives get white spots?
It’s a harmless, common mold. You can take the olives out, rinses them in warm water, strain the brine through a coffee filter, wash the jar, and put the brine and olive back in, it you like. That will slow down the growth of the white mold. A clove or two of garlic will also slow down the white mold.
Can I store olives in water?
You can help olives stay fresh longer by storing them unopened in the pantry where the temperature is always less than 75 degrees Fahrenheit. Once opened, the olives should be kept in the fridge, fully submerged in their liquid.
Can olives be stored without brine?
Olives that don’t have brine and olives that are marinated should be refrigerated. If you want olives to keep for the longest time possible, then storing them in a safe plastic container in the fridge is your best bet.
How do you preserve black olives at home?
Cut two slits in each olive and then place these into a tub filled with water to cover. Keep the olives submerged and change the water every day, for 6 days. On the next day, instead of re-filling with water, pour over some plain white vinegar (the cheap no-name brands will do) and leave overnight.
Does Salt prevent botulism?
Added solutes (salt or sugar) grab a portion of the water in your food, limiting its availability to the microbes. A concentration of about 10% salt will effectively prevent germination of Botulism spores in your canned food.
What's the difference between green olives and black olives?
It may surprise you to learn that the only difference between green olives and black olives is ripeness; unripe olives are green, whereas fully ripe olives are black.
Why are black olives in a can and green olives in a jar?
The end product is raw, cured and crisp, olives. The short of it is — black olives are “always” in a can because the canning process is what creates the desired sweetness; and green olives are “always” in a jar because the final product is expected to be a crispy raw olive, not a cooked one.
Should olives float or sink?
The fruit will sink to the bottom of the container, but some will float to the top. This should be avoided since otherwise the part of the olives that is not immersed in the liquid will turn brown.
Can mold grow on olives in brine?
If olives get a white scum around top of brine they are still safe to use. This is just the fermentation happening. If they develop a blue mold, the consensus of the group was that they should not be used. Do not use fresh vegetables or fresh herbs as they develop molds.
Does olive juice go bad?
This “best by” date is usually 6 months from the time of bottling. Once opened we recommend that the product be stored in a cool and dry place, or refrigerated.
Are black olives real olives?
Black olives, though labeled as “ripe” on supermarket cans, actually aren’t: these, a California invention, are green olives that have been cured in an alkaline solution, and then treated with oxygen and an iron compound (ferrous gluconate) that turns their skins a shiny patent-leather black.
What are the mildest olives?
Cerignola Olives A popular table olive, the Cerignola has a very mild, unobtrusive flavor as it is usually packed in a weak brine. You can find them here and here.